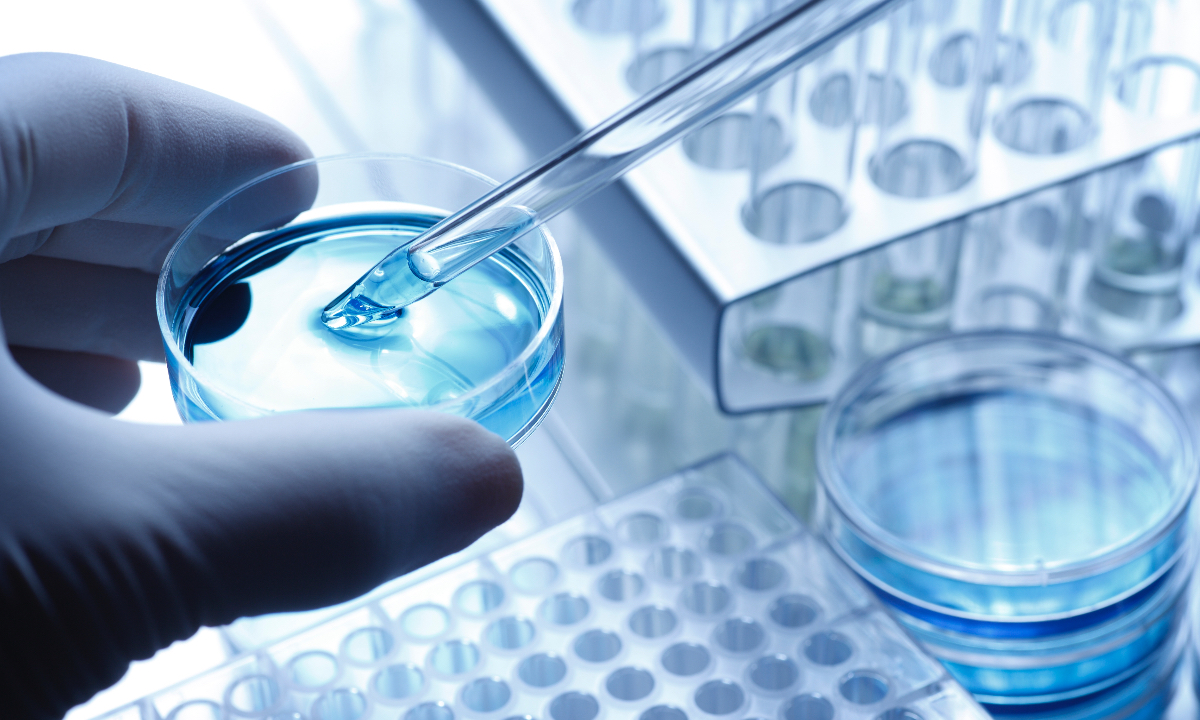

China rolls out pilot ethical reviews measures on scientific and technological activities
Photo: VCG
Chinese authorities released on Sunday the pilot review measures of science and technology ethics. As the new round of scientific and technological revolution and industrial transformation accelerate progress, ethical issues have become a common challenge facing the whole world.
China’s Ministry of Science and Technology together with nine other government departments such as the Ministry of Education and the Ministry of Industry and Information Technology, released the comprehensive and universal review measures that cover ethical reviews on science and technologies activities, in a bid to focus on solving a series of problems such as unclear responsibilities and lack of universal review standards.
A series of measures and relevant provisions were proposed from the perspectives of improving the system, standardizing procedures, strict standards and strengthening supervision.
The review methods define the main scope of the ethical reviews on science and technology, specify the responsible entities for ethical review, the criteria for establishing the science and technology ethics (review) committees and their organizational and operational mechanisms. The measures also outline the basic procedures for ethical reviews, and determine the content and standards for ethical reviews.
According to the pilot measures, scientific and technological activities involving human participants, including research activities such as testing, surveys, and observations using human beings as research objects, as well as scientific activities using human biological samples and personal information data, shall be subject to ethical review in accordance with these measures.
Meanwhile, scientific and technological activities involving laboratory animals shall be subject to the ethical review as well.
Besides, science and technology activities that do not directly involve humans or laboratory animals but may pose ethical risks and challenges in areas such as life and health, ecological environment, public order and sustainable development shall also be subject to ethical review.
The pilot measures also stipulate that institutions and units engaged in scientific activities in life sciences, medicine, artificial intelligence and other fields, whose research content involves sensitive areas of science and technology ethics, should establish a review committee on scientific and technological ethics.
The review committee on scientific and technological ethics should conduct reviews if the scientific activities involve humans participants, to make sure fair and reasonable recruitment programs, lawful and compliant collection, storage, use and disposal of biological samples, and the processing of personal privacy data, biometric information and other information complied with the relevant provisions on the protection of personal information.
The committee also should make sure the reasonable and appropriate protection plan for the legal rights and interests of research participants, including compensation, treatment for injuries, as well as the special protection of vulnerable groups.
Scientific and technological activities involving laboratory animals should adhere to the principles of replacement, reduction and refinement and make sure the lawful and reasonable source of the laboratory animals. The technical operations of breeding, using, and disposing laboratory animals should comply with animal welfare standards.
Technological activities involving data and algorithms, including activities related to the collection, storage, processing and use of data, as well as the research and development of new data technologies, should comply with relevant national regulations on data security and the protection of personal information.
Risk monitoring and emergency response plans of data security must be appropriate.
The design, implementation and application of algorithms, models and systems should adhere to principles such as fairness, justice, transparency, reliability and controllability, in accordance with relevant national requirements.
The review measures also outline a list of emerging scientific and technological activities that may pose greater ethical risk and challenges, which have to be revalued by experts.
Activities include the researches on the synthetic creation of new species that has a significant impact on human life and health, values, ecological environment, researches involving the introduction of human stem cells into animal embryos or fetuses and further gestation of the individual in an animal uterus, and basic researches that involve altering the genetic material or genetic characteristics of human germ cells, fertilized eggs and pre-implantation embryos.
Clinical researches on invasive brain-machine interfaces for the treatment of neurological and psychiatric disorders and development of human-machine fusion systems with a strong impact on human subjective behaviors, psychological emotions and overall health, should also be revalued by experts, according to the review measures.
This list will be dynamically adjusted according to needs.
Global Times


